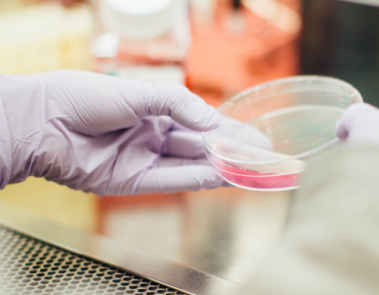

WICHTIGE MITTEILUNG!
Liebe Patientinnen, liebe Patienten.
Wir möchten Sie darauf hinweisen, daß die Ordination wegen Urlaub an folgenden Tagen geschlossen ist:
27. 10. – 31. 10. 2025
Während unserer Schließtage übernimmt Dr. Albert Syen, Schüttaustrasse 20-40/9/3+4, 1220 Wien, die ärztliche Vertretung.
Aktuelle Informationen finden sie auf Dr. Nicole Walter-Publig | Praktische Ärztin in 1220 Wien – DocFinder.at
Danke für Ihr Verständnis. Dr. Nicole Walter-Publig.
Wichtiger Hinweis zum Thema Impfen
Liebe Patientinnen, liebe Patienten,
Falls Sie eine Grippeimpfung für 2025/26 erhalten wollen, bitte wir Sie an uns ein Email zu senden in dem Sie ihren Namen, Ihre Sozialversicherungsnummer und Telefonnummer anführen. Senden Sie das Email an ordination@walter-publig.at. Sobald wird den Impfstoff erhalten, setzen wir Sie bezüglich Terminvereinbarung telefonisch in Kenntnis. Impftermine finden ausschließlich außerhalb der Ordinationszeiten statt.
Homepage Intro
Dr. Nicole Walter-Publig
Tel: 01/2828787
Fax: 01/282878714
Aktuelle Informationen finden sie auf: Dr. Nicole Walter-Publig | Praktische Ärztin in 1220 Wien – DocFinder.at
Ordination Dr. Nicole Walter-Publig
Wir freuen uns, Sie in unserer Ordination begrüssen zu dürfen.
Unsere Ordinationszeiten sind:
Montag 08:45 – 12:45
Dienstag 08:30 – 12:30
Mittwoch 08:30 – 12:30
Donnerstag 15:00 – 19:00
Freitag 07:00 – 11:00 (Blutabnahme nach Terminvereinbarung)
Folgende Leistungen bieten wir für Sie an:
- Umfassende ärztliche Betreuung
- Vorsorgeuntersuchung
- EKG
- Blutabnahme
- Harnkontrolle
- Blutzuckermessungen
- Infiltration und Infusionen
- Beratungen
- Impfberatungen/Impfungen
- OP-Freigaben
- Hausbesuche, Therapie aktiv Diabetes Mellitus
- u.a.
Impfnachtragungen im E-Impfpass
Es besteht die Möglichkeit, bereits getätigte Impfungen in den E-Impfpass nachtragen zu lassen. Jedoch ausgenommen sind Covid-19 Impfungen. Da es sich hier um einen sehr hohen Aufwand handelt, verrechnen wir eine Bearbeitungsgebühr in der Höhe von € 25,–.
Bitte zu beachten, daß Annahmeschluss 1 Stunde vor Ordinationsende ist. Bei starkem Patientenaufkommen wird dieser Termin vorgezogen.
Ordination Dr. Nicole Walter-Publig
ORDINATIONSZEITEN
Montag 08:45 – 12:45
Dienstag 08:30 – 12:30
Mittwoch 08:30 – 12:30
Donnerstag 15:00 – 19:00
Freitag 07:00 – 11:00
Annahmeschluss: 60 Minuten vor Ordinationsende
Ausfolgung von Rezepten ist bis zum Ordinationsende möglich.
e-card
Wir bitten Sie bei jedem Besuch Ihre e-card mitzunehmen.
Sollten Sie das erste Mal zu uns kommen, ist auch ein amtlicher Lichtbildausweis vorzuweisen.
Sollten Sie Ihre e-card vergessen, ist ein Einsatz von 30,– Euro (brutto) zu entrichten, den Sie nach Vorweis der e-card wieder zurückbekommen.
ANAMNESE
Um eine umfassende Anamnese und bestmögliche Behandlung durchführen zu können, bringen Sie bitte eine Liste Ihrer einzunehmenden Medikamente sowie bereits vorhandene Befunde zu Ihrem ersten Arztbesuch mit.
ORDINATIONSZEITEN
Montag 08:45 – 12:45
Dienstag 08:30 – 12:30
Mittwoch 08:30 – 12:30
Donnerstag 15:00 – 19:00
Freitag 07:00 – 11:00
Annahmeschluss:
- 30 Minuten vor Ordinationsende
- 60 Min bei Infusionen
Ausfolgung von Rezepte ist bis zum Ordinationsende möglich.

e-card
Wir bitten Sie bei jedem Besuch Ihre e-card mitzunehmen.
Sollten Sie das erste Mal zu uns kommen, ist auch ein amtlicher Lichtbildausweis vorzuweisen.
Sollten Sie Ihre e-card vergessen, ist ein Einsatz von 30,– Euro (brutto) zu entrichten, den Sie nach Vorweis der e-card wieder zurückbekommen.

ANAMNESE
Um eine umfassende Anamnese und bestmögliche Behandlung durchführen zu können, bringen Sie bitte eine Liste Ihrer einzunehmenden Medikamente sowie bereits vorhandene Befunde zu Ihrem ersten Arztbesuch mit.
über mich
DR. NICOLE WALTER-PUBLIG
ÄRZTIN FÜR ALLGEMEINMEDIZIN
Diplome der Ärztekammer:
Notarztdiplom
DFP-Fortbildungsdiplom
ÖAK Diplom Schularzt
ÖAK Diplom Arbeitsmedizin
Sprachen: Deutsch, Français, English, Espanol

Dr. Nicole Walter-Publig
ÄRZTIN FÜR ALLGEMEINMEDIZIN
Diplome der Ärztekammer:
- Notarztdiplom
- DFP-Fortbildungsdiplom
- ÖAK Diplom Schularzt
- ÖAK Diplom Arbeitsmedizin
Sprachen: Deutsch, Français, English, Espanol
Wichtige Daten
Urlaub
Urlaub
Von 16.06. – 23.06.2025, von 17.07. – 01.08.2025 und von 27.10. – 31.10.2025 ist die Ordination wegen Urlaub geschlossen. Dr. Albert Syen Vertretung.
Urlaubsvertretung
Urlaubsvertretung
Dr. Albert Syen, Schüttaustrasse 20-40/9/3+4, 1220 Wien
Notruf
Notruf
Wichtige Rufnummern in Notfällen:
- Wiener Rettung 144
- Ärztefunkdienst 141
- Vergiftungszentrale 01/4064343
Blutabnahme
Blutabnahme
Blutabnahme findet jeden Freitag in unserer Ordination von 07:00 - 08:00 nach vorheriger Terminvereinbarung statt.
Auf das jeweilige Bild klicken, um Info sichtbar zu machen
Leistungen
Auf das jeweilige Bild klicken, um Info Seite zu öffnen